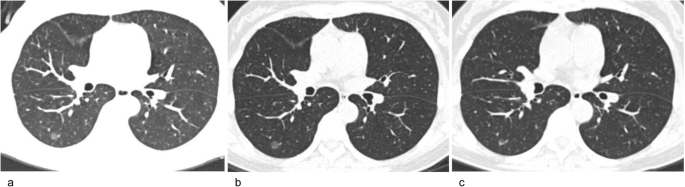
figure 5

Abstract
Objectives
To calculate the pooled incidence of interval growth after long-term follow-up and identify predictors of interval growth in subsolid nodules (SSNs) on chest CT.
Methods
A search of MEDLINE (PubMed), Cochrane Library, Web of Science Core Collection, and Embase was performed on November 08, 2021, for relevant studies. Patient information, CT scanner, and SSN follow-up information were extracted from each included study. A random-effects model was applied along with subgroup and meta-regression analyses. Study quality was assessed by the Newcastle–Ottawa scale, and publication bias was assessed by Egger’s test.
Results
Of the 6802 retrieved articles, 16 articles were included and analyzed, providing a total of 2898 available SSNs. The pooled incidence of growth in the 2898 SSNs was 22% (95% confidence interval [CI], 15–29%). The pooled incidence of growth in the subgroup analysis of pure ground-glass nodules was 26% (95% CI: 12–39%). The incidence of SSN growth after 2 or more years of stability was only 5% (95% CI: 3–7%). An initially large SSN size was found to be the most frequent risk factor affecting the incidence of SSN growth and the time of growth.
Conclusions
The pooled incidence of SSN growth was as high as 22%, with a 26% incidence reported for pure ground-glass nodules. Although the incidence of growth was only 5% after 2 or more years of stability, long-term follow-up is needed in certain cases. Moreover, the initial size of the SSN was the most frequent risk factor for growth.
Key Points
• Based on a meta-analysis of 2898 available subsolid nodules in the literature, the pooled incidence of growth was 22% for all subsolid nodules and 26% for pure ground-glass nodules.
• After 2 or more years of stability on follow-up CT, the pooled incidence of subsolid nodule growth was only 5%.
• Given the incidence of subsolid nodule growth, management of these lesions with long-term follow-up is preferred.
Similar content being viewed by others
Avoid common mistakes on your manuscript.
Introduction
Subsolid nodules (SSNs), sometimes named ground-glass nodules, can be categorized as pure ground-glass nodules (pGGNs) and mixed ground-glass nodules (mGGNs) [1]. According to the guidelines of the National Comprehensive Cancer Network and the Fleischner Society for the management of SSNs, thoracic CT should be conducted every 6–12 months for solitary pGGNs (6 mm or larger) or every 3–6 months for mGGNs (6 mm or larger) and multiple SSNs to determine if the nodules are persistent [1, 2]. Although the growth of SSNs is indolent, the probability of malignancy in persistent SSNs is higher than that of solid nodules [3].
Persistent SSNs usually consist of atypical adenomatous hyperplasia, adenocarcinoma in situ, minimally invasive adenocarcinoma, or invasive adenocarcinoma [4, 5]. Because of the indolent biological behavior of adenocarcinoma in situ, it was reclassified as a precursor glandular lesion in 2021 and was found to not require surgery [4]. Numerous reports have indicated that long-term follow-up CT (e.g., for at least 5 years) is recommended for SSNs because of their indolent clinical course [1, 3, 6,7,8,9,10]. If the SSN grows or develops a solid component, surgery should be considered because of the higher risk for invasive adenocarcinoma in these nodules [7,8,9,10]. Up to a 10% solitary pGGN growth rate has been reported, even in SSNs measuring 5 mm or smaller, with a long-term follow-up of at least 5 years [11]. Lee JH et al found that only 2/235 (2%) SSNs measuring 6 mm or larger after 5 years of stability showed subsequent growth [9]. However, to our surprise, Lee HW et al found that subsequent SSN growth was identified in 27/208 (13.0%) that had been stable for 5 years [3]. Therefore, the long-term natural course of SSNs is still unclear.
To our knowledge, the pooled incidence of interval growth after long-term follow-up has not yet been systematically evaluated. Thus, the purpose of this systematic review and meta-analysis was to estimate the incidence of interval growth after long-term follow-up and identify the predictors of interval growth in SSNs on chest CT. We also calculated the pooled growth incidence of SSNs after at least 2 years of stability.
Materials and methods
This systematic review and meta-analysis were conducted and reported according to the Preferred Reporting Items for Systematic Reviews and Meta-Analysis (PRISMA) guidelines [12]. This study was exempt from ethical approval at our institution. The review was registered on PROSPERO before initiation (registration no. CRD42021293524).
Search strategy
A comprehensive search of MEDLINE (PubMed), Cochrane Library, Web of Science Core Collection, and Embase was performed on November 08, 2021, to identify studies reporting the growth of SSNs. The search terms were as follows: (“ground-glass nodule*” OR “subsolid nodule*” OR “part-solid nodule*” OR “lung nodule*”) AND (“growth” OR “nature course” OR “natural history” OR “follow up”) AND (“computed tomography” OR “CT”). The detailed search strategy is described in the Supplementary Materials. Only original articles were considered for analysis, and there was no limit on the year or language of publication.
Eligibility criteria
The first selection was performed by two independent readers with 8 years and 5 years of experience in thoracic imaging (L.W. and C.G., respectively). First, all the articles obtained from the above four databases were combined, and then duplicate articles were removed. Second, the relevant articles were screened by their titles and abstracts. Finally, the relevant articles were reevaluated through full-text retrieval to find eligible articles.
Articles that reported the growth of SSNs after follow-up and/or predictors of interval growth were included. These included studies in which SSNs were followed up for two or more years and studies that followed up the SSNs for less than 2 years but reported SSN growth ≥ 2 years of stability. The following articles were excluded: (1) case reports, conference abstracts, comments, editorials, letters to the editor, and guidelines; (2) studies based on all types of nodules and those that did not specifically mention SSNs; (3) articles with missing data or overlapping patients; (4) studies in which the duration of follow-up was less than 2 years or unknown and those that did not report SSN growth after ≥ 2 years of stability; and (5) studies in which all patients had a history of malignant tumors or residual SSNs after surgical treatment of the dominant lung cancer.
Data extraction
For each analyzed article, the recorded data included first author; country; year of publication; study design; CT scanner; tube voltage or tube current; reconstruction slice thickness; window width, window level; plain or enhanced CT; reconstruction algorithm; number of patients and nodules; patient age; number of pGGNs and mGGNs; baseline size of the SSNs; nodule measurements; follow-up period; definition of growth; definition of SSN; number of growths; number of growths after ≥ 2 years of stability; growth patterns; pathological diagnosis; interval between detection and interval growth; odds ratio and 95% confidence interval (CI) in multivariate analysis for growth; and hazard ratio in Cox analysis for the time of the growth.
The purpose of this study was to calculate the pooled incidence of interval growth after long-term follow-up and find the predictors of interval growth in SSNs on chest CT. Descriptive statistics were used to summarize the characteristics, growth incidence, and risk factors for SSNs. The incidence of interval growth after long-term follow-up was pooled. Subgroup analysis was conducted separately for pGGNs and mGGNs. If a sufficient amount of homogeneous data were available, the pooled incidence of interval growth after at least 2 years of stability was calculated. Another subgroup analysis was conducted separately for subsolid nodule growth after 2 years of stability or more for SSNs ≥ 5 mm and < 5 mm.
Statistical analysis
A random-effects model was used to calculate the pooled incidence of growth and its 95% CI. Heterogeneity between the studies was assessed using both Q and I2 statistics. The heterogeneity was considered high if I2 was greater than 50%, and high heterogeneity may affect the extent to which generalizable conclusions can be formed [13, 14]. Analysis was conducted using Stata 16 software (StataCorp) and R software version 4.2.1 (https://www.r-project.org/). The methodological quality of the observational studies included in the review was appraised with the Newcastle–Ottawa Scale (NOS) [15]. Study quality was evaluated by NOS scores, and divided into high (score of 7–9), moderate (score of 4–6), and poor (score of 0–3) [16]. The Egger test was used to assess publication bias. Finally, p < .05 was therefore considered to indicate a significant difference.
Results
Literature search
The literature search flow diagram is shown in Fig. 1. A total of 16 articles from 6802 initially retrieved articles were included in the study after strict application of the inclusion and exclusion criteria [3, 7,8,9,10,11, 17,18,19,20,21,22,23,24,25,26]. The detailed criteria of the terms for SSN follow-up in the included studies were provided in Supplementary Materials, Table E1. The 16 included articles, with a total of 2898 available SSNs, were published from 2012 [17] to 2020 [9].
Study characteristics
The main characteristics of the analyzed studies are shown in Tables 1, 2, 3, and 4. CT scanner information of the included studies is shown in Table 1. All the study patients were from Asia (6 Japan, 4 China, 6 Korea). Only one study was prospective [11], and the other studies were retrospective [3, 7,8,9,10, 17,18,19,20,21,22,23,24,25,26]. The reconstruction slice thickness ranged from 0.625 to 5 mm. Of the studies that reported the reconstruction slice thickness, thirteen of 14 (92.86%) reported values of 3 mm or less [3, 7, 8, 10, 11, 18, 20,21,22,23,24,25,26], while only one (7.14%) reported values of 1 to 5 mm [9]. In total, 12/14 (85.71%) studies used two or more CT scanners [3, 7, 9,10,11, 17, 18, 20, 21, 23, 24, 26].
Except for one article that was based on all pulmonary nodules but reported an SSN subgroup [22], the other articles were all based only on SSNs [3, 7,8,9,10,11, 17,18,19,20,21, 23,24,25,26] (Table 2). There were 2545 pGGNs, 283 mGGNs [3, 7,8,9,10,11, 17,18,19,20,21, 23,24,25,26], and 70 SSNs that were not classified [22] (Table 2). Fourteen studies reported the sex of the patients with SSNs [3, 7,8,9,10,11, 17,18,19,20,21, 23,24,25], and 1182/2218 (53.29%) were female. The age of the patients ranged from 20 to 92 years [3, 7, 8, 11, 17,18,19,20, 24].
Definition of growth and growth patterns
The definitions of SSN growth in the studies were as follows: 2 mm or more increase in mean/longest diameter [3, 7, 9,10,11, 17,18,19,20,21, 24,25,26]; 2 mm or more increase in the solid portion [3, 7, 9, 10, 25]; new occurrence of solid parts [3, 7, 9, 10, 21, 23,24,25,26]; 2 mm or more increase in the 3D diameter [24]; an increase of at least 30% in volume or mass [24]; increase in volume by at least 20% [22, 23]; new occurrence of a solid part and ≥ 2 mm decrease in overall size [7]; and increase in tumor size/the ratio of the maximum diameter of the consolidation relative to the maximum tumor diameter in the lung window [8]. The growth patterns of the included SSNs are shown in Table 2.
Overall incidence of SSN growth
The pooled overall incidence of growth in all included studies was 22% (95% CI, 15–29%) (Fig. 2). In the subgroup analysis, the pooled incidence of pGGN growth was 26% (95% CI: 12–39%). The remaining SSNs, minus the pure ground-glass nodules were included in a subgroup of the remaining SSNs. The pooled incidence of growth was not different between pGGNs (26%, 95% CI: 12–39%) and the remaining SSNs (19%, 95% CI: 11–26%) (p = 0.37) (Fig. 2). High heterogeneity was found among the studies in the overall incidence of growth in SSNs (Q = 425.35, p < 0.001, I2 = 97.83%), pGGNs (Q =142.79, p < 0.001, I2 = 97.25%), and remaining SSNs (Q = 221.13, p < 0.001, I2 = 97.10%) (Fig. 2).
Incidence of growth of SSNs after ≥ 2 years of stability
After 2 or more years of stability (ranging from 2 to 5 years), the incidence of SSN growth was only 5% (95% CI: 3–7%) [3, 7,8,9,10, 17, 19, 20, 22]. The heterogeneity of this analysis was lower than that of the overall analysis (Q = 35.40, p < 0.01, I2 = 77.00% vs. Q = 425.35, p < 0.001, I2 = 97.83%) (Figs. 2 and 3). Another subgroup analysis based on the initial mean/median diameter of SSNs was conducted (Table E2 and Fig. 3b). When we removed the study with an initial mean/median diameter < 5 mm [3] for subgroup analysis, there was no heterogeneity in the subsequent analysis (Q = 8.22, p = 0.31, I2 = 15.00%). The incidence of growth after 2 years of stability or more for SSNs with an initial diameter ≥ 5 mm was 4% (95% CI: 3–5%) (Fig. 3b). Patient examples of stable and growing SSNs after long-term follow-up are shown in Figs. 4 and 5, respectively.
Forest plot of the incidence of subsolid nodule growth after 2 years of stability or more (a) and forest plot of the incidence of subsolid nodule growth after 2 years of stability or more for the subgroup analysis for SSNs ≥ 5 mm and < 5 mm (b). Diameter: the initial mean/median diameter of the SSNs
A 70-year-old man with a stable subsolid nodule after long-term follow-up CT. a Transverse plain CT section of a part-solid nodule in the right upper lobe. The nodule size (longest diameter) was 9 mm on transverse CT images at baseline. b Follow-up CT obtained 5 years after baseline showed that the nodule is stable. c The nodule was still stable after a 10-year follow-up
A 49-year-old woman with subsolid nodule growth after long-term follow-up CT. a Baseline CT. Transverse plain CT of a pure ground-glass nodule in the right lower lobe. The nodule size (longest diameter) was 8 mm on transverse CT images. b Follow-up CT obtained 5 years after baseline. The pure ground-glass nodule was stable. c Follow-up CT obtained 6 years after the baseline CT. A new solid component appeared in the nodule, and its size decreased from 8 to 6 mm. The growing nodule was a minimally invasive adenocarcinoma, as confirmed by pathology
SSNs confirmed by pathology
A total of 14 studies [3, 7,8,9,10,11, 17,18,19,20,21,22,23, 26] reported that some SSNs were confirmed by surgery or biopsy after long-term follow-up. Of these 329 SSNs, only 4/329 (1.2%) were benign (3 interstitial fibrosis; 1 pulmonary capillary hemangiomatosis with foci). A total of 325/329 (98.8%) SSNs were pathologically proven to be lung cancers or precursor glandular lesions. A total of 307/329 (93.3%) SSNs were lung adenocarcinomas or precursor glandular lesions, two SSNs were pleomorphic carcinoma or squamous cell carcinoma, five SSNs were bronchi-alveolar carcinomas and the other eleven SSNs were not classified.
Predictive factors for SSN growth and for the time to SSN growth
Multivariate analysis was performed with a logistic regression model to predict the incidence of SSN growth after long-term follow-up [7, 10, 20, 21, 24, 25] (Table 3). An initially large SSN size was found to be a risk factor affecting the incidence of SSN growth in 5/6 studies [7, 10, 20, 24, 25]. The other risk factors for the incidence of SSN growth varied among studies, such as age ≥ 65 years and the presence of a solid portion (mGGN) [7, 20] (Table 3). Multivariate Cox proportional hazards regression analysis was conducted to predict the time to SSN growth [3, 10, 21, 23, 24, 26] (Table 4). We also found that the size of the SSN was the most frequent risk factor for the time to SSN growth in 5/6 studies [10, 21, 23, 24, 26] (Table 4).
Risk of bias assessment
After assessing the studies with the Newcastle–Ottawa scale, 14 of the 16 studies (87.5%) were scored as 4, one (6.25%) was scored as 5, and one (6.25%) was scored as 6 (Supplementary Materials, Table E3). All the studies’ quality was assessed as moderate quality level. There was some publication bias by means of Egger’s test (p < 0.001).
Discussion
The management of persistent SSNs is a topic of importance because an increasing number of SSNs are being identified on chest CT [3, 27]. Clinically, follow-up CT is preferred over immediate surgery because of the indolent behavior, slower growth rate, and good prognosis of SSNs, even if they are malignant [28,29,30,31]. Long-term follow-up after the first CT is necessary to accurately assess SSN growth. Because the long-term course of SSNs remains unclear and larger sample studies with long-term follow-up CT are lacking, we performed a systematic review and meta-analysis focused on SSNs with at least 2 years of follow-up. The overall incidence of SSN growth was 22% (95% CI, 15–29%), while the incidence of growth was only 5% (95% CI: 3–7%) after at least 2 years of stability, but both had high heterogeneity. In the studies, we excluded studies in which all patients had a history of malignant tumors, such as breast cancer [32] or had previously undergone surgical treatment of the dominant lung cancer [33, 34]. The natural course of these residual SSNs or incidentally detected SSNs after surgery may be different from other SSNs, and these SSNs also have different follow-up strategies [35].
In our study, the high heterogeneity in the incidence of growth may be caused by many factors, such as different inclusion criteria, definitions of growth, and initial sizes of the SSNs. The initial diameters of the SSNs in the included studies were varied from smaller than 5 to 20 mm [11, 17, 22, 26]. The definition of SSN growth also differed among the studies. The new occurrence of solid parts was not defined as growth in five studies [11, 17,18,19,20], while it was defined as growth in the majority of studies even if the size decreased [3, 7, 9, 10, 21, 23,24,25,26, 36]. Accurate measurements of SSNs are important to assess their growth and the recommendations from the Fleischner Society addressed pulmonary nodule measurements on CT in 2017 [37]. It was recommended that the average long- and short-axis diameters be used to measure nodule size and a 2-mm threshold should be defined as nodule growth [37,38,39,40,41]. Because SSNs are three-dimensional lesions, an increase in volume or mass could more reliably reflect the growth of SSNs. An increase of at least 20–30% in volume or mass was also used to define SSN growth [22,23,24]. In addition, to assess the growth of SSNs accurately, we should also consider other morphological changes, such as shape, borders, and internal texture [37]. With the development of advanced semiautomated and automated measurement techniques, the assessment of SSN growth may become more consistent and accurate in the future [42,43,44].
Additionally, we focused on the incidence of SSN growth after 2 years or more of stability. However, Lee et al [3] reported that 13% of SSNs (27/208) had growth even after 5 years of stability, which is a higher rate than the pooled incidence of growth in the other studies (13% vs. 5%). The possible reasons for this high heterogeneity may be as follows. First, SSNs managed with long-term follow-up are likely to be smaller. Larger persistent SSNs or mGGNs with solid components ≥ 5 mm are more likely to be removed through surgery or other therapies. Some studies [45, 46] have reported that an SSN lesion measuring ≥ 10 mm is a risk factor for invasive adenocarcinomas. The size of SSNs on the initial follow-up CT may be one of the factors that influence the incidence of growth. For example, the initial diameter of the SSNs was smaller than 5 mm in the study by Lee et al [3], but the diameters in the other studies were larger than or equal to 5 mm [7,8,9,10, 17, 19, 20, 22]. Therefore, we conducted a subgroup analysis for the SSNs with an initial diameter of ≥ 5 mm and < 5 mm (Fig. 3b).
In these different subgroups, the factors affecting the incidence of growth and the time to growth were analyzed. We found that the size of the SSNs was the factor most frequently associated with growth and the time to growth [7, 10, 20, 21, 23,24,25,26]. Therefore, the guidelines state that SSNs can be reasonably and conveniently managed clinically according to their size [1, 2]. Among all 329 SSNs confirmed by pathology, only 4 of 329 (1.2%) were benign, and 307 of 329 (93.3%) were lung adenocarcinomas or precursor glandular lesions. Indeed, SSNs are considered a common form and an indolent subtype of lung adenocarcinoma.
Our study has some limitations. First, the heterogeneity of SSNs in the included studies was high, even in the subgroup analysis of pGGNs. Hence, we further conducted a subgroup analysis of SSNs with at least 2 years of stability and then conducted another subgroup analysis of the initial mean/median diameter ≥ 5 mm. Second, the quality of most included studies was limited according to the Newcastle–Ottawa scale. Finally, some publication bias cannot be ignored. SSNs with a larger size or irregular morphology might be more likely to be treated with aggressive measures such as surgery rather than follow-up. Therefore, most of the analyzed SSNs in the study were smaller than 10 mm, which might have led to some bias.
In conclusion, this systematic review and meta-analysis showed that long-term follow-up CT for SSNs is important and necessary. The overall incidence of growth among SSNs was 22% after a follow-up of 2 years or more. In addition, the pooled incidence of SSN growth after at least 2 years of stability was only 5%. It is anticipated that the present guidelines may serve to standardize our current management of SSNs, but further clarification of their natural history is needed for more precise management.
Abbreviations
- 95% CI:
-
95% confidence interval
- mGGN:
-
Mixed ground-glass nodule
- pGGN:
-
Pure ground-glass nodule
- SSN:
-
Subsolid nodule
References
MacMahon H, Naidich DP, Goo JM et al (2017) Guidelines for management of incidental pulmonary nodules detected on CT images: from the Fleischner Society 2017. Radiology 284:228–243
National Comprehensive Cancer Network (2022) National Comprehensive Cancer Network Clinical Practice Guidelines in Non-Small Cell Lung Cancer. Version 1. https://www.nccn.org/guidelines/guidelines-detail?category=1&id=1450. Accessed 25 Dec 2021
Lee HW, Jin KN, Lee JK et al (2019) Long-term follow-up of ground-glass nodules after 5 years of stability. J Thorac Oncol 14:1370–1377
WHO Classification of Tumours Editorial Board (2021) Thoracic Tumours. WHO Classification of Tumours. 5th edition. https://publications.iarc.fr/Book-And-Report-Series/Who-Classification-Of-Tumours/Thoracic-Tumours-2021. Accessed 15 September 2022
Travis WD, Brambilla E, Noguchi M et al (2011) international association for the study of Lung Cancer/American Thoracic Society/European Respiratory Society International Multidisciplinary Classification of Lung Adenocarcinoma. J Thorac Oncol 6:244–285
Lee JH, Park CM, Lee SM, Kim H, McAdams HP, Goo JM (2016) Persistent pulmonary subsolid nodules with solid portions of 5 mm or smaller: Their natural course and predictors of interval growth. Eur Radiol 26:1529–1537
Cho J, Kim ES, Kim SJ et al (2016) Long-term follow-up of small pulmonary ground-glass nodules stable for 3 years: implications of the proper follow-up period and risk factors for subsequent growth. J Thorac Oncol 11:1453–1459
Sawada S, Yamashita N, Sugimoto R, Ueno T, Yamashita M (2016) Long-term outcomes of patients with ground-glass opacities detected using CT scanning. Chest 151:308–315
Lee JH, Lim WH, Hong JH et al (2020) Growth and clinical impact of 6-mm or larger subsolid nodules after 5 years of stability at chest CT. Radiology 295:448–455
Sato Y, Fujimoto D, Morimoto T et al (2017) Natural history and clinical characteristics of multiple pulmonary nodules with ground glass opacity. Respirology 22:1615–1621
Kakinuma R, Muramatsu Y, Kusumoto M et al (2015) Solitary Pure Ground-Glass Nodules 5 mm or Smaller: Frequency of Growth. Radiology 276:873–882
Moher D, Liberati A, Tetzlaff J, Altman DG, PRISMA Group (2009) Preferred reporting items for systematic reviews and meta-analyses: the PRISMA statement. PLoS Med 6:e1000097
Borenstein M, Hedges LV, Higgins JPT, Rothstein HR (2010) A basic introduction to fixed-effect and random-effects models for meta-analysis. Res Synth Methods 1:97–111
Deeks JJ, Higgins JPT, Altman DG (editors) Chapter 10: analysing data and undertaking meta-analyses. In: Higgins JPT, Thomas J, Chandler J, Cumpston M, Li T, Page MJ, Welch VA (editors). Cochrane Handbook for Systematic Reviews of Interventions version 6.2 (updated February 2021). Cochrane, 2021. www.training.cochrane.org/handbook. Accessed 20 April 2022
Wells G, Shea B, O’Connell D, et al The Newcastle-Ottawa Scale (NOS) for assessing the quality of nonrandomised studies in meta-analyses. http://www.ohri.ca/programs/clinical_epidemiology/oxford.asp. Accessed 25 Dec 2021
Misra DP, Rathore U, Patro P, Agarwal V, Sharma A (2021) Corticosteroid monotherapy for the management of Takayasu arteritis-a systematic review and meta-analysis. Rheumatol Int 41:1729–1742
Takahashi S, Tanaka N, Okimoto T et al (2012) Long term follow-up for small pure ground-glass nodules: implications of determining an optimum follow-up period and high-resolution CT findings to predict the growth of nodules. Jpn J Radiol 30:206–217
Chang B, Hwang JH, Choi YH et al (2013) Natural history of pure ground-glass opacity lung nodules detected by low-dose CT scan. Chest 143:172–178
Kobayashi Y, Fukui T, Ito S et al (2013) How long should small lung lesions of ground-glass opacity be followed? J Thorac Oncol 8:309–314
Lee SW, Leem CS, Kim TJ et al (2013) The long-term course of ground-glass opacities detected on thin-section computed tomography. Respir Med 107:904–910
Eguchi T, Kondo R, Kawakami S et al (2014) Computed tomography attenuation predicts the growth of pure ground-glass nodules. Lung Cancer 84:242–247
Shin KE, Lee KS, Yi CA, Chung MJ, Shin MH, Choi YH (2014) Subcentimeter lung nodules stable for 2 years at LDCT: long-term follow-up using volumetry. Respirology 19:921–928
Qi LL, Wu BT, Tang W et al (2019) Long-term follow-up of persistent pulmonary pure ground-glass nodules with deep learning-assisted nodule segmentation. Eur Radiol 30:744–755
Shi Z, Deng J, She Y et al (2019) Quantitative features can predict further growth of persistent pure ground-glass nodule. Quant Imaging Med Surg 9:283–291
Gao C, Yan J, Luo Y et al (2020) The growth trend predictions in pulmonary ground glass nodules based on radiomic CT features. Front Oncol 10:580809
Qiu T, Ru X, Yin K, Yu J, Song Y, Wu J (2020) Two nomograms based on CT features to predict tumor invasiveness of pulmonary adenocarcinoma and growth in pure GGN: a retrospective analysis. Jpn J Radiol 38:761–770
McWilliams A, Tammemagi MC, Mayo JR et al (2013) Probability of cancer in pulmonary nodules detected on first screening CT. N Engl J Med 369:910–919
Hattori A, Matsunaga T, Hayashi T, Takamochi K, Oh S, Suzuki K (2017) Prognostic impact of the findings on thin-section computed tomography in patients with subcentimeter non-small cell lung cancer. J Thorac Oncol 12:954–962
Miyoshi T, Aokage K, Katsumata S, Tane K, Ishii G, Tsuboi M (2019) Ground-glass opacity is a strong prognosticator for pathologic stage IA lung adenocarcinoma. Ann Thorac Surg 108:249–255
Callister MEJ, Sasieni P, Robbins HA (2021) Overdiagnosis in lung cancer screening. Lancet Respir Med 9:7–9
Yankelevitz DF, Henschke CI (2021) Overdiagnosis in lung cancer screening. Transl Lung Cancer Res 10:1136–1140
Xu H, Pu XH, Yu TF et al (2020) Incidence and natural course of CT-detected pulmonary ground-glass nodules in Chinese women with breast cancer: a retrospective, single-center, long-term follow-up study in 4682 consecutive patients. Acta Radiol 61:175–183
Kim HS, Lee HJ, Jeon JH et al (2013) Natural history of ground-glass nodules detected on the chest computed tomography scan after major lung resection. Ann Thorac Surg 96:1952–1957
Bongiolatti S, Corzani R, Borgianni S et al (2018) Long-term results after surgical treatment of the dominant lung adenocarcinoma associated with ground-glass opacities. J Thorac Dis. 10:4838–4848
Araujo-Filho JAB, Halpenny D, McQuade C et al (2021) Management of pulmonary nodules in oncologic patients: AJR Expert Panel Narrative Review. AJR Am J Roentgenol. 216:1423–1431
Kaneda H, Nakano T, Taniguchi Y, Saito T, Konobu T, Saito Y (2014) A decrease in the size of ground glass nodules may indicate the optimal timing for curative surgery. Lung Cancer 85:213–217
Bankier AA, MacMahon H, Goo JM, Rubin GD, Schaefer-Prokop CM, Naidich DP (2017) Recommendations for Measuring Pulmonary Nodules at CT: a Statement from the Fleischner Society. Radiology 285:584–600
Henschke CI, Yip R, Yankelevitz DF, Smith JP, International Early Lung Cancer Action Program Investigators (2013) Definition of a positive test result in computed tomography screening for lung cancer: a cohort study. Ann Intern Med 158:246–252
Kazerooni EA, Armstrong MR, Amorosa JK et al (2015) ACR CT accreditation program and the lung cancer screening program designation. J Am Coll Radiol 12:38–42
Callister ME, Baldwin DR, Akram AR, et al (2015) British Thoracic Society guidelines for the investigation and management of pulmonary nodules. Thorax 70: ii1–ii54
Revel MP, Bissery A, Bienvenu M, Aycard L, Lefort C, Frija G (2004) Are two-dimensional CT measurements of small noncalcified pulmonary nodules reliable? Radiology 231:453–458
Hwang EJ, Goo JM, Kim HY, Yi J, Yoon SH, Kim Y (2021) Implementation of the cloud-based computerized interpretation system in a nationwide lung cancer screening with low-dose CT: comparison with the conventional reading system. Eur Radiol 31:475–485
Kim H, Park CM, Hwang EJ, Ahn SY, Goo JM (2018) Pulmonary subsolid nodules: value of semi-automatic measurement in diagnostic accuracy, diagnostic reproducibility and nodule classification agreement. Eur Radiol 28:2124–2133
Scholten ET, de Hoop B, Jacobs C et al (2013) Semi-automatic quantification of subsolid pulmonary nodules: comparison with manual measurements. PLoS One 8:e80249
Lee SM, Park CM, Goo JM, Lee HJ, Wi JY, Kang CH (2013) Invasive pulmonary adenocarcinomas versus preinvasive lesions appearing as ground-glass nodules: differentiation by using CT features. Radiology 268:265–273
Lee GD, Park CH, Park HS et al (2019) Lung adenocarcinoma invasiveness risk in pure ground-glass opacity lung nodules smaller than 2 cm. Thorac Cardiovasc Surg 67:321–332
Funding
The study was supported by the National Natural Science Foundation of China [Grant No.82102128], the Medical Health Science and Technology Project of Zhejiang Province (Grant No. 2022KY230) and the “Pioneer” and “Leading Goose” R&D Program of Zhejiang (Grant No. 2022C03046).
Author information
Authors and Affiliations
Corresponding author
Ethics declarations
Guarantor
The scientific guarantor of this publication is Maosheng Xu.
Conflict of interest
The authors of this manuscript declare no relationships with any companies whose products or services may be related to the subject matter of the article.
Statistics and biometry
No complex statistical methods were necessary for this paper.
Informed consent
Written informed consent was not required for this study because this was a systematic review and meta-analysis.
Ethical approval
Institutional Review Board approval was not required because this was a systematic review and meta-analysis.
Methodology
• retrospective
• Systematic review
• meta-analysis
Additional information
Publisher’s note
Springer Nature remains neutral with regard to jurisdictional claims in published maps and institutional affiliations.
Supplementary information
ESM 1
(DOCX 33 kb)
Rights and permissions
Open Access This article is licensed under a Creative Commons Attribution 4.0 International License, which permits use, sharing, adaptation, distribution and reproduction in any medium or format, as long as you give appropriate credit to the original author(s) and the source, provide a link to the Creative Commons licence, and indicate if changes were made. The images or other third party material in this article are included in the article's Creative Commons licence, unless indicated otherwise in a credit line to the material. If material is not included in the article's Creative Commons licence and your intended use is not permitted by statutory regulation or exceeds the permitted use, you will need to obtain permission directly from the copyright holder. To view a copy of this licence, visit http://creativecommons.org/licenses/by/4.0/.
About this article
Cite this article
Wu, L., Gao, C., Kong, N. et al. The long-term course of subsolid nodules and predictors of interval growth on chest CT: a systematic review and meta-analysis. Eur Radiol 33, 2075–2088 (2023). https://doi.org/10.1007/s00330-022-09138-y
Received:
Revised:
Accepted:
Published:
Issue Date:
DOI: https://doi.org/10.1007/s00330-022-09138-y